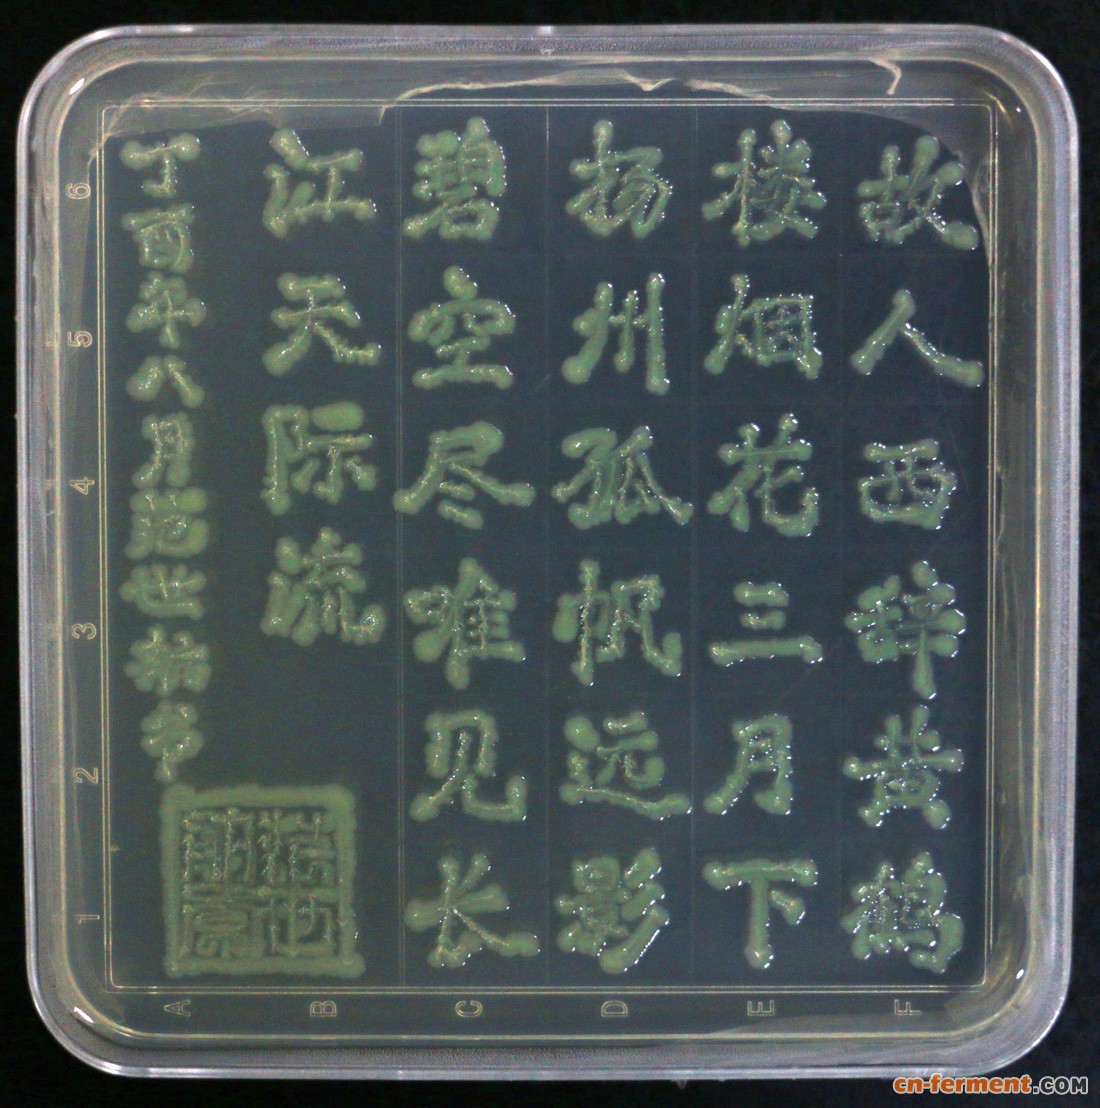
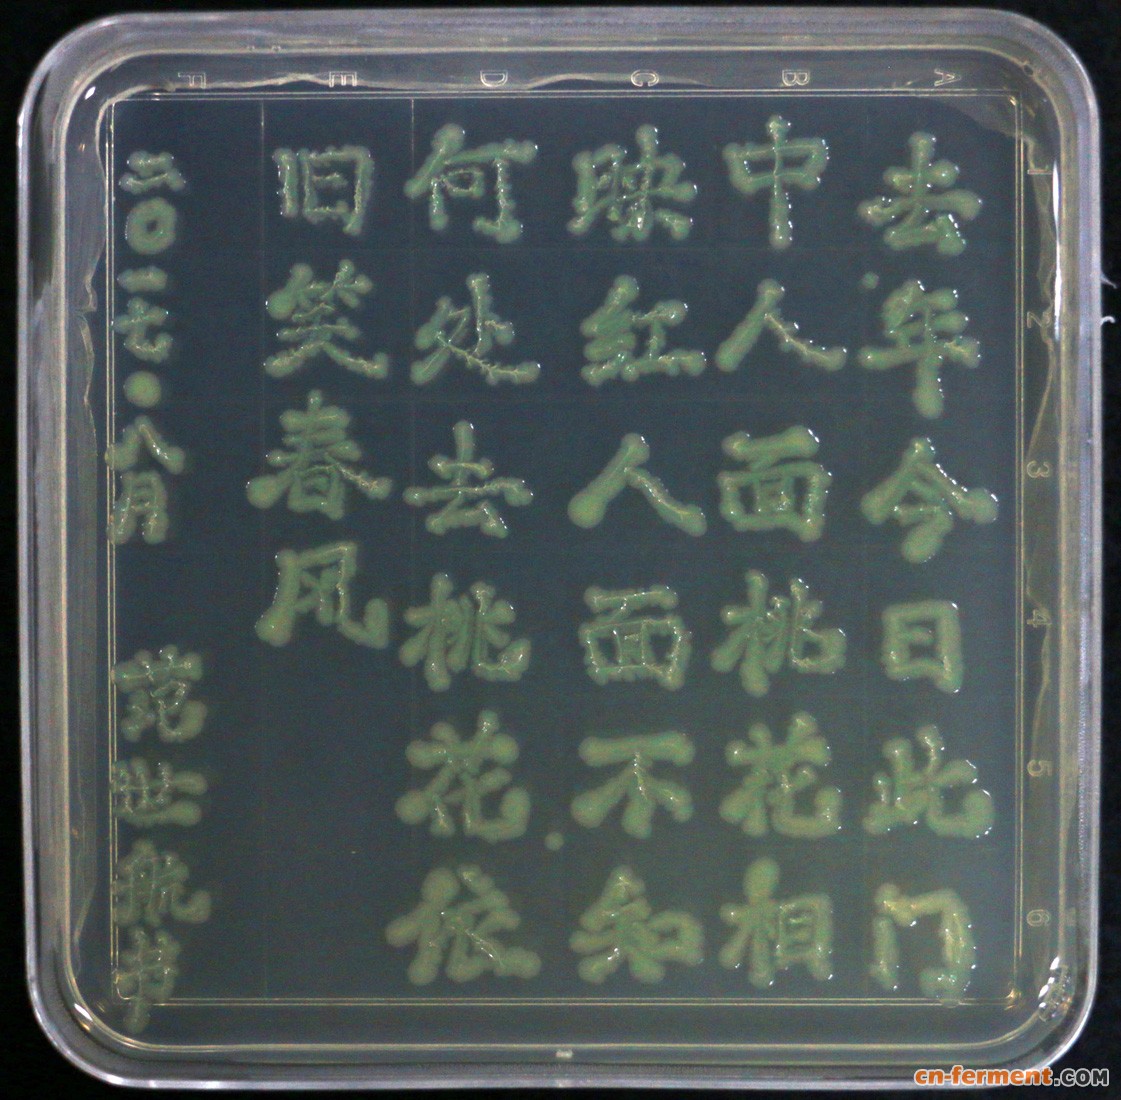
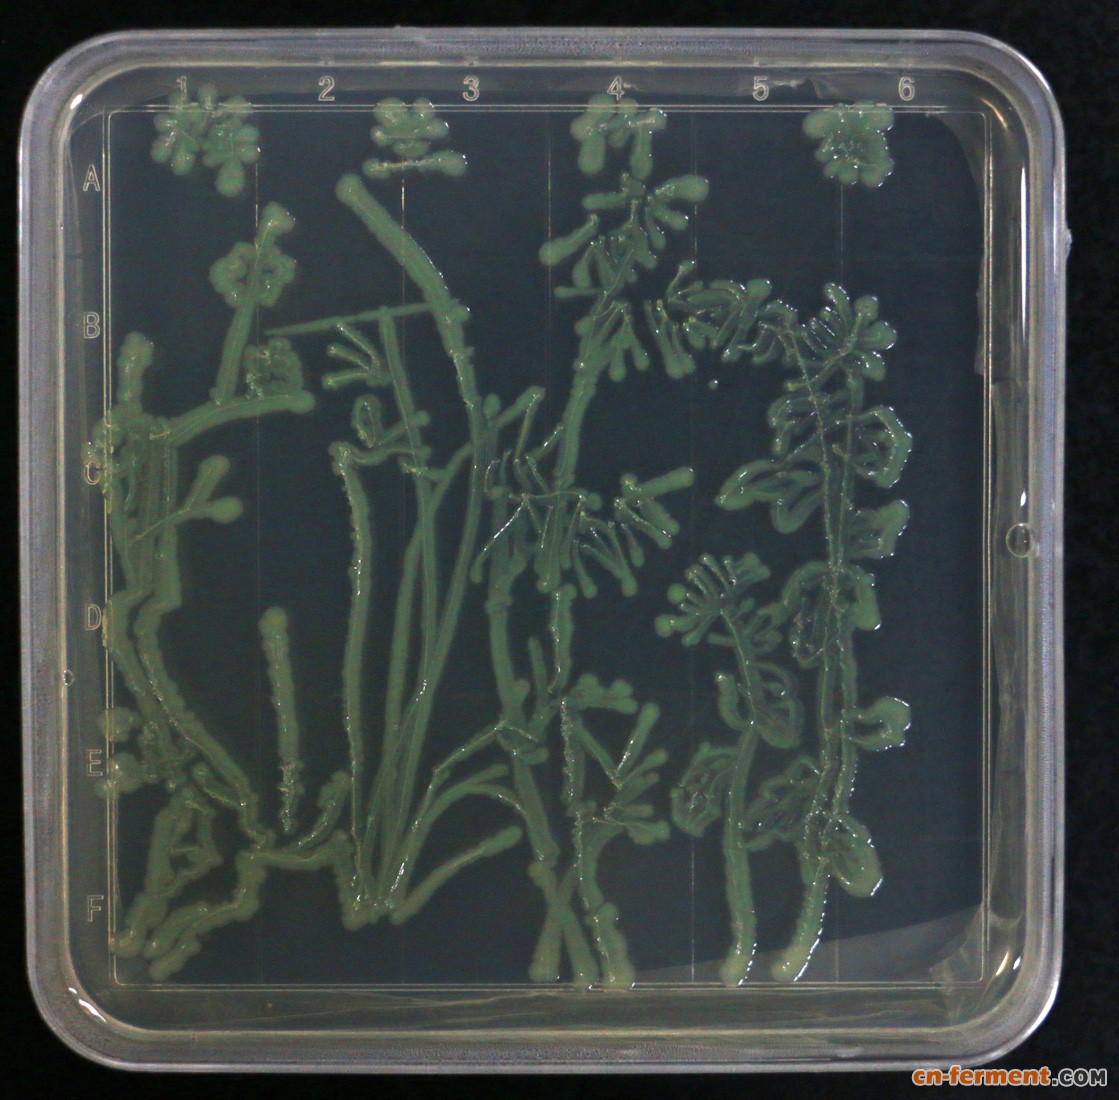
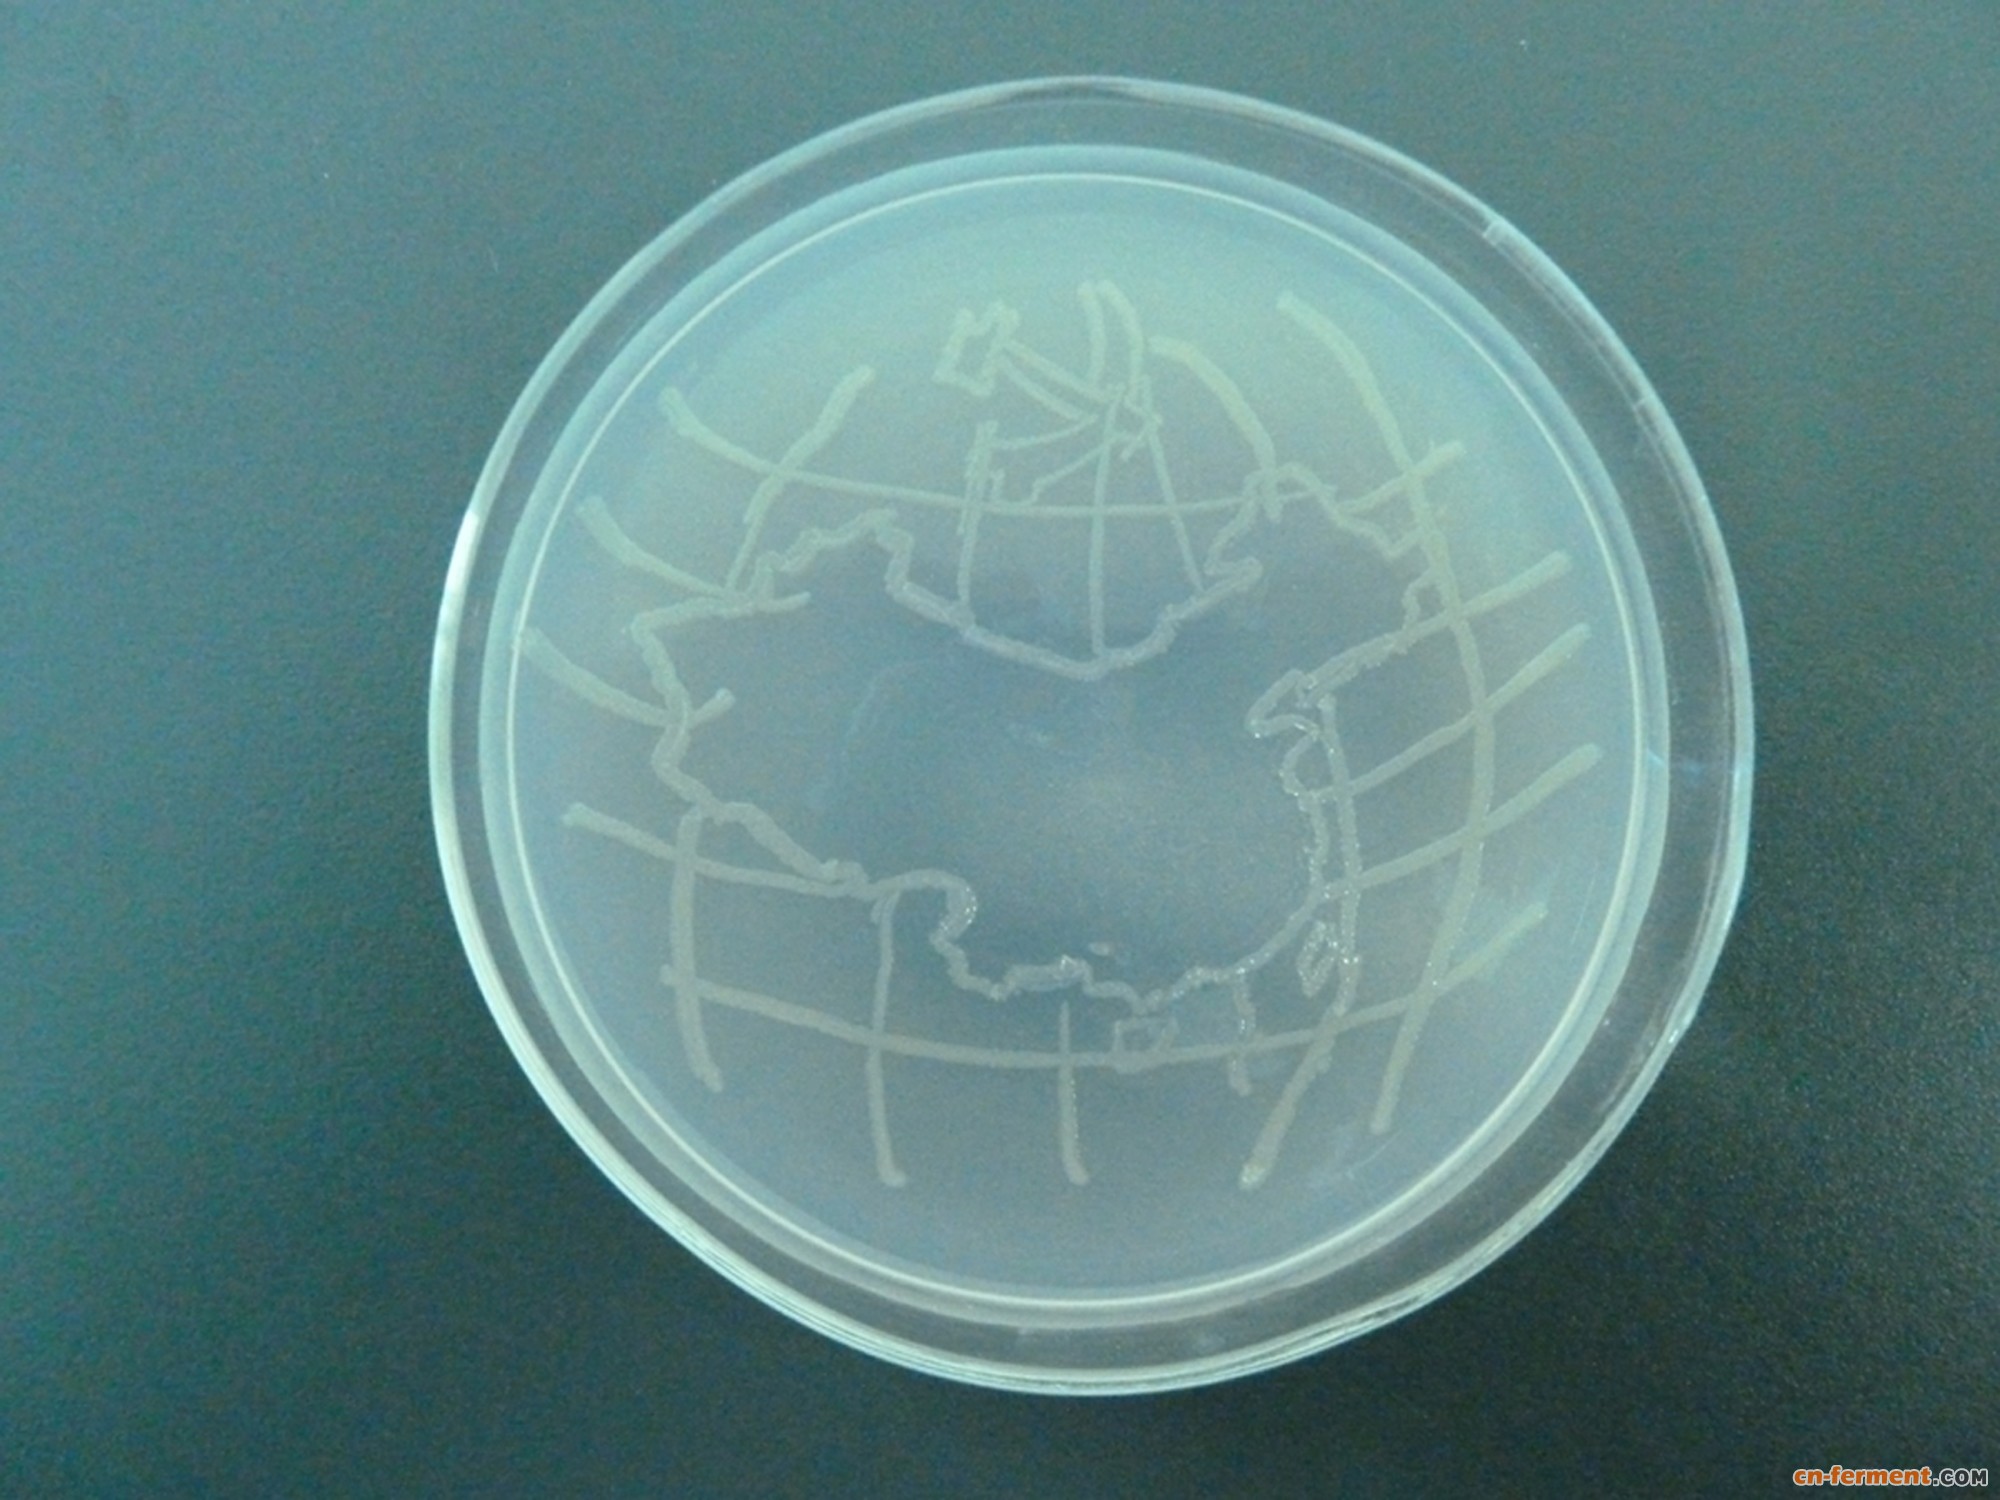
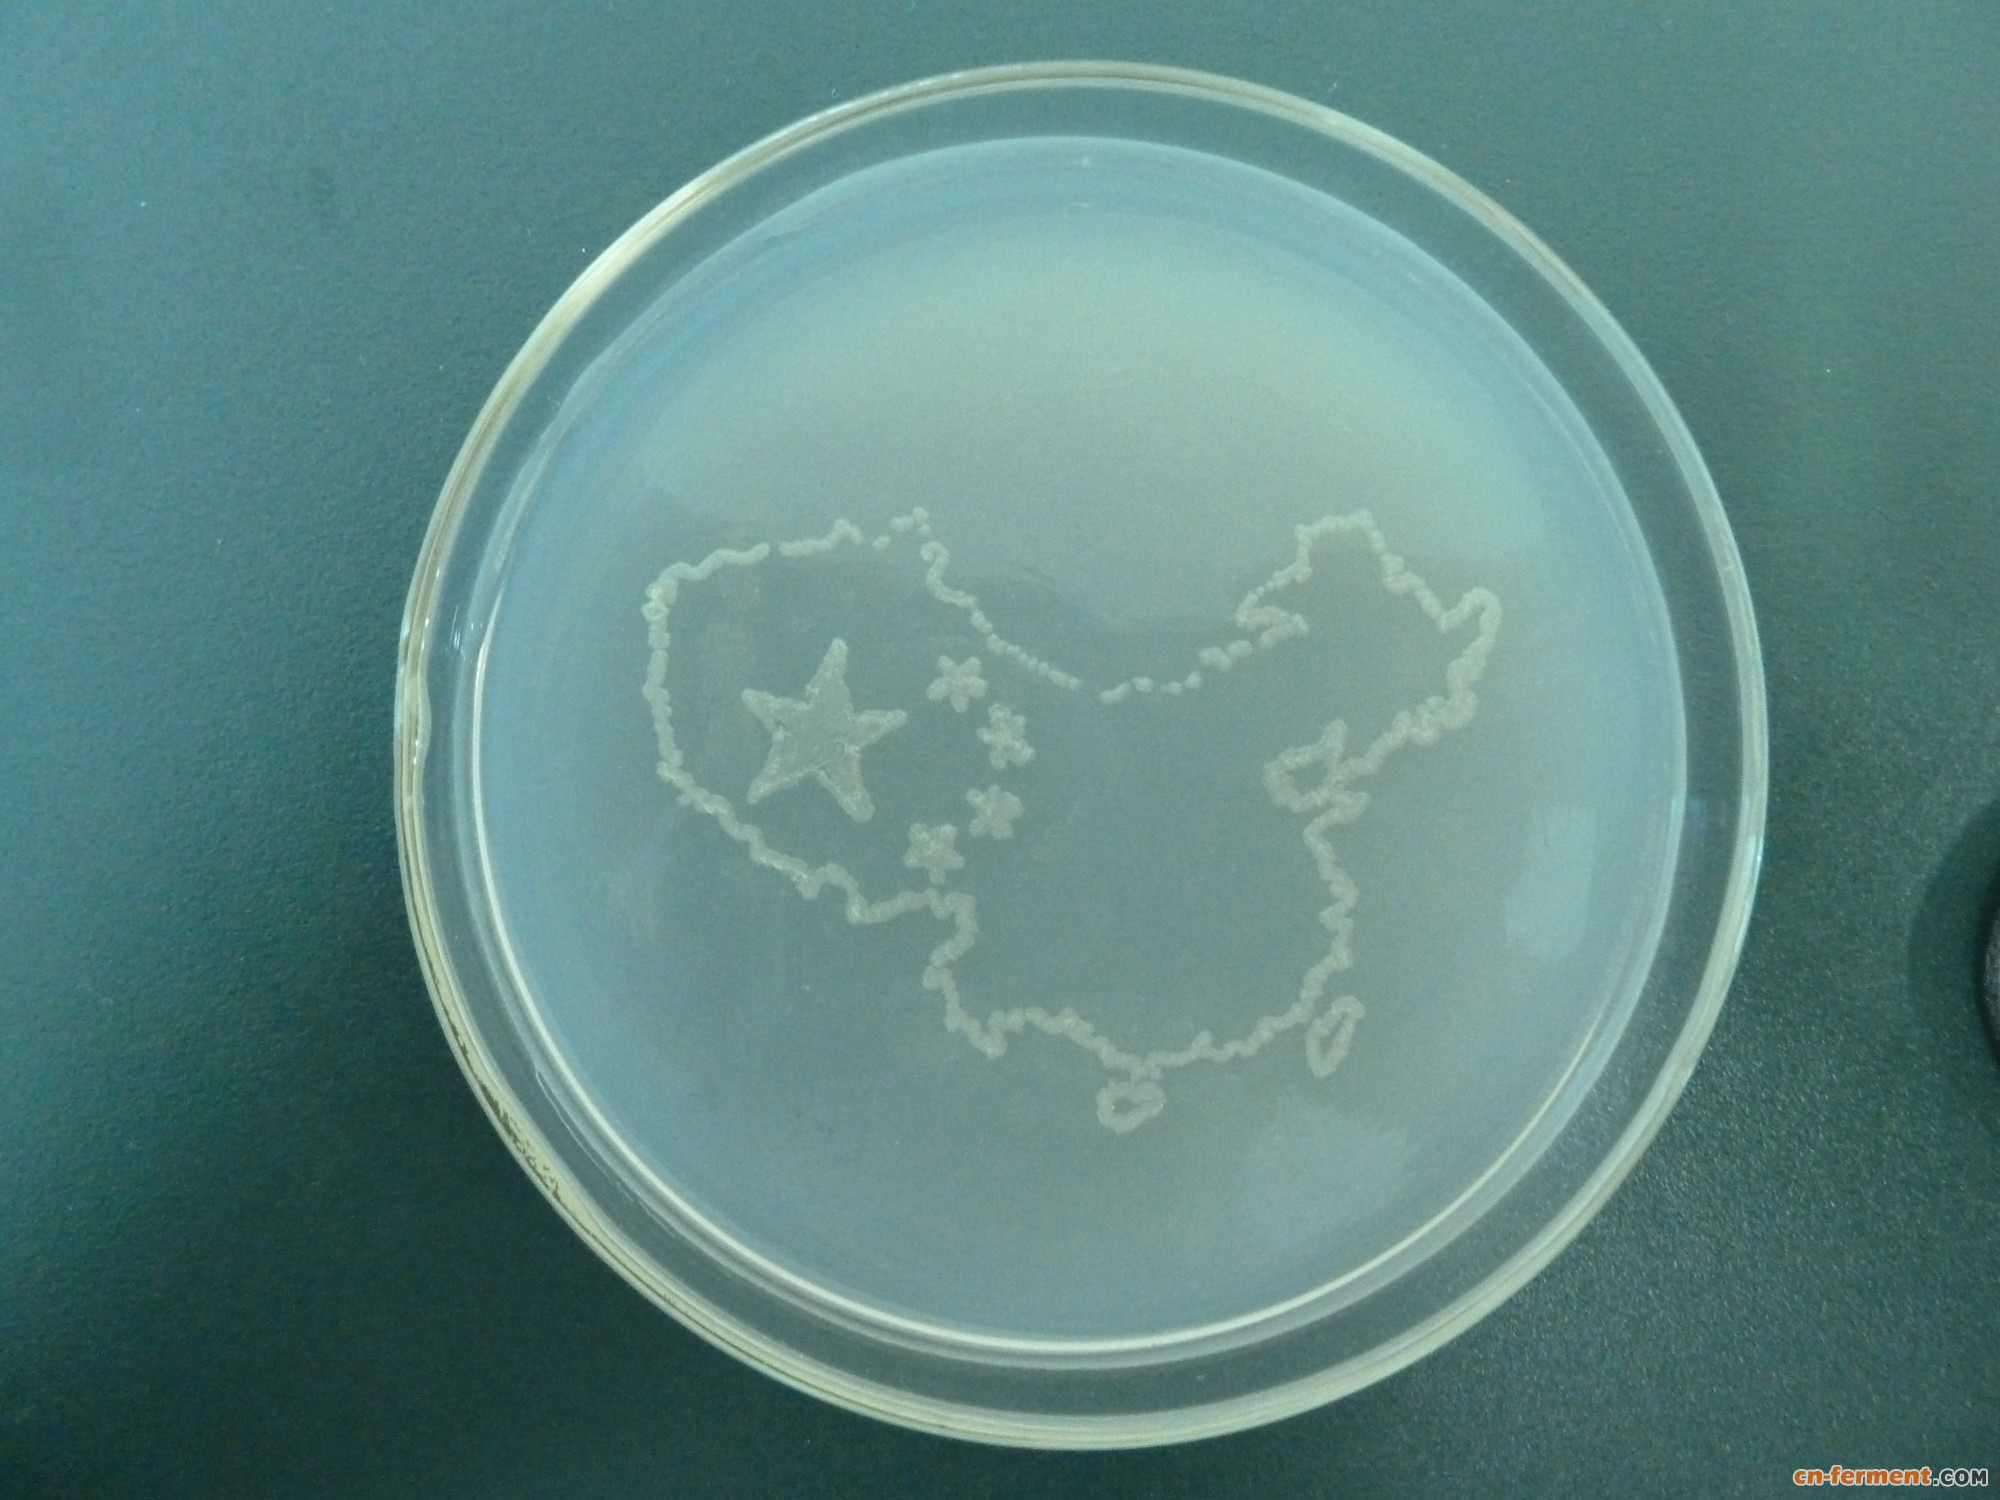
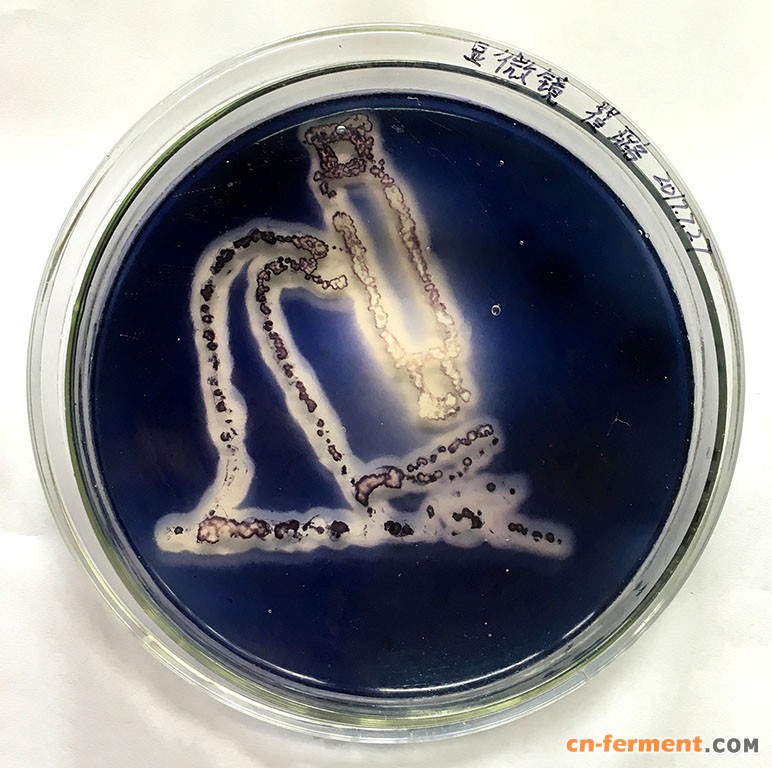
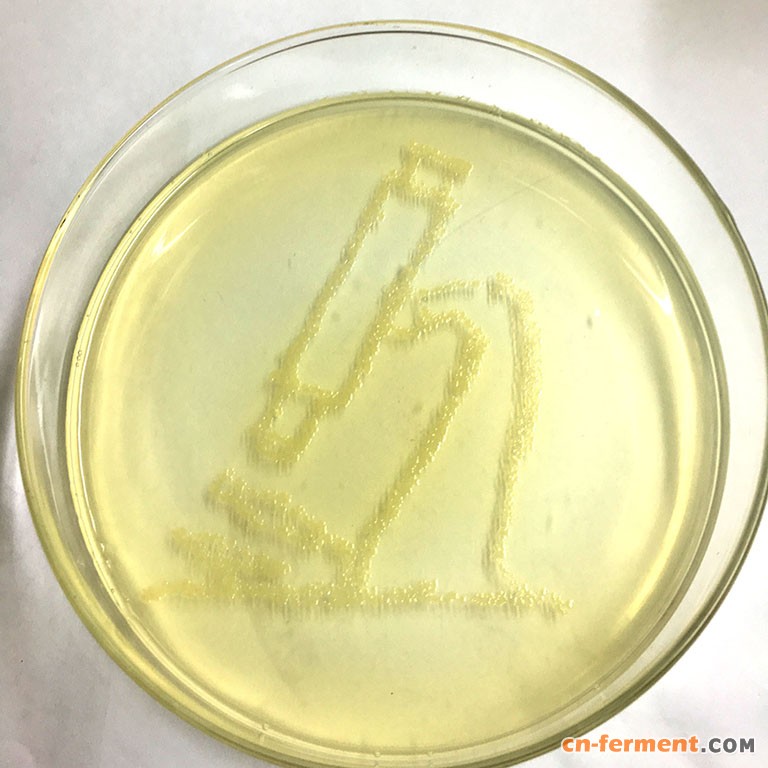
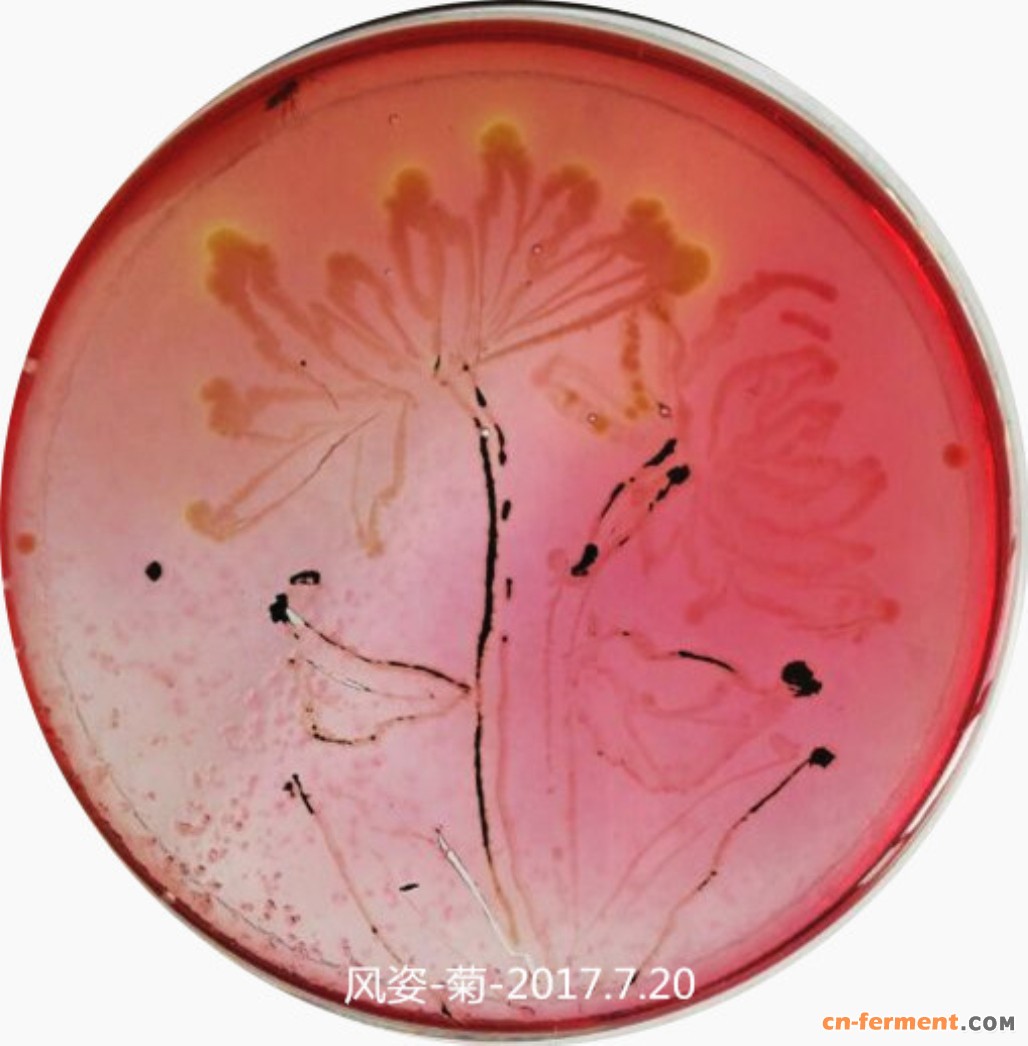
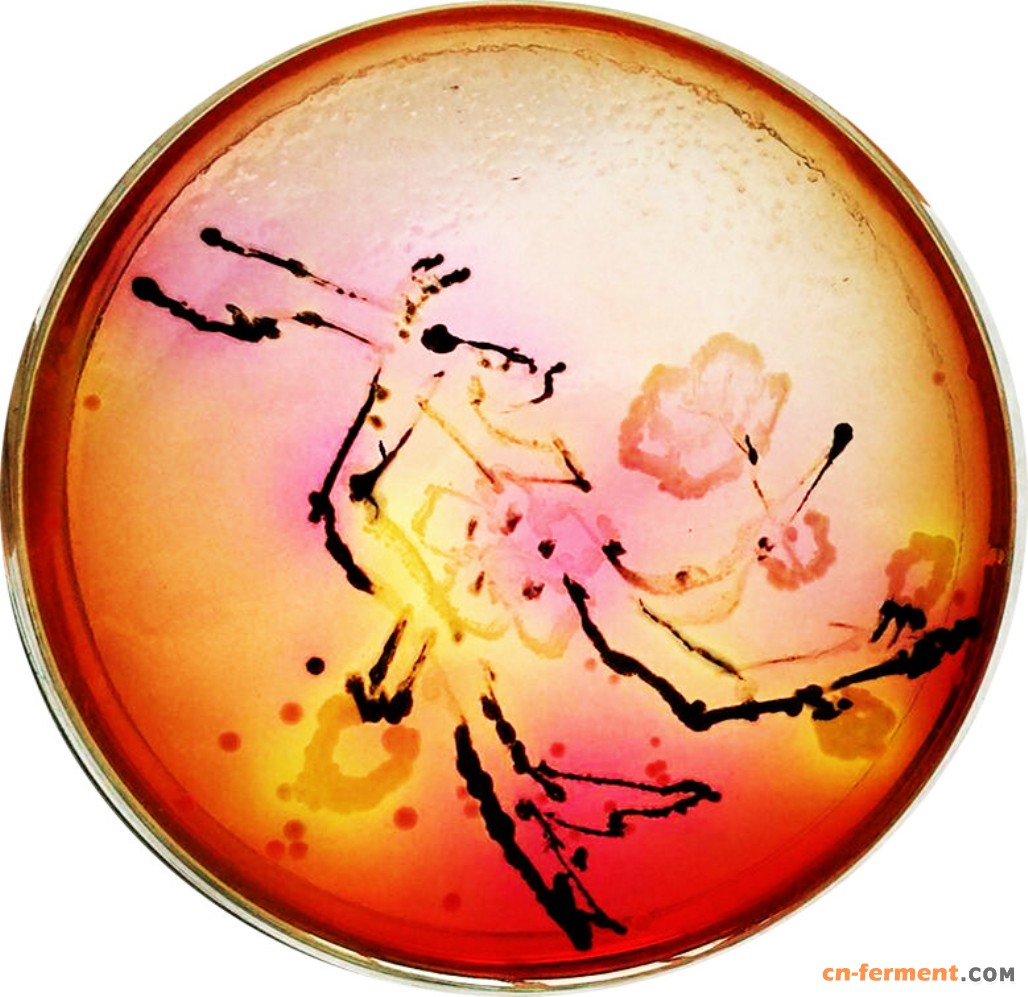
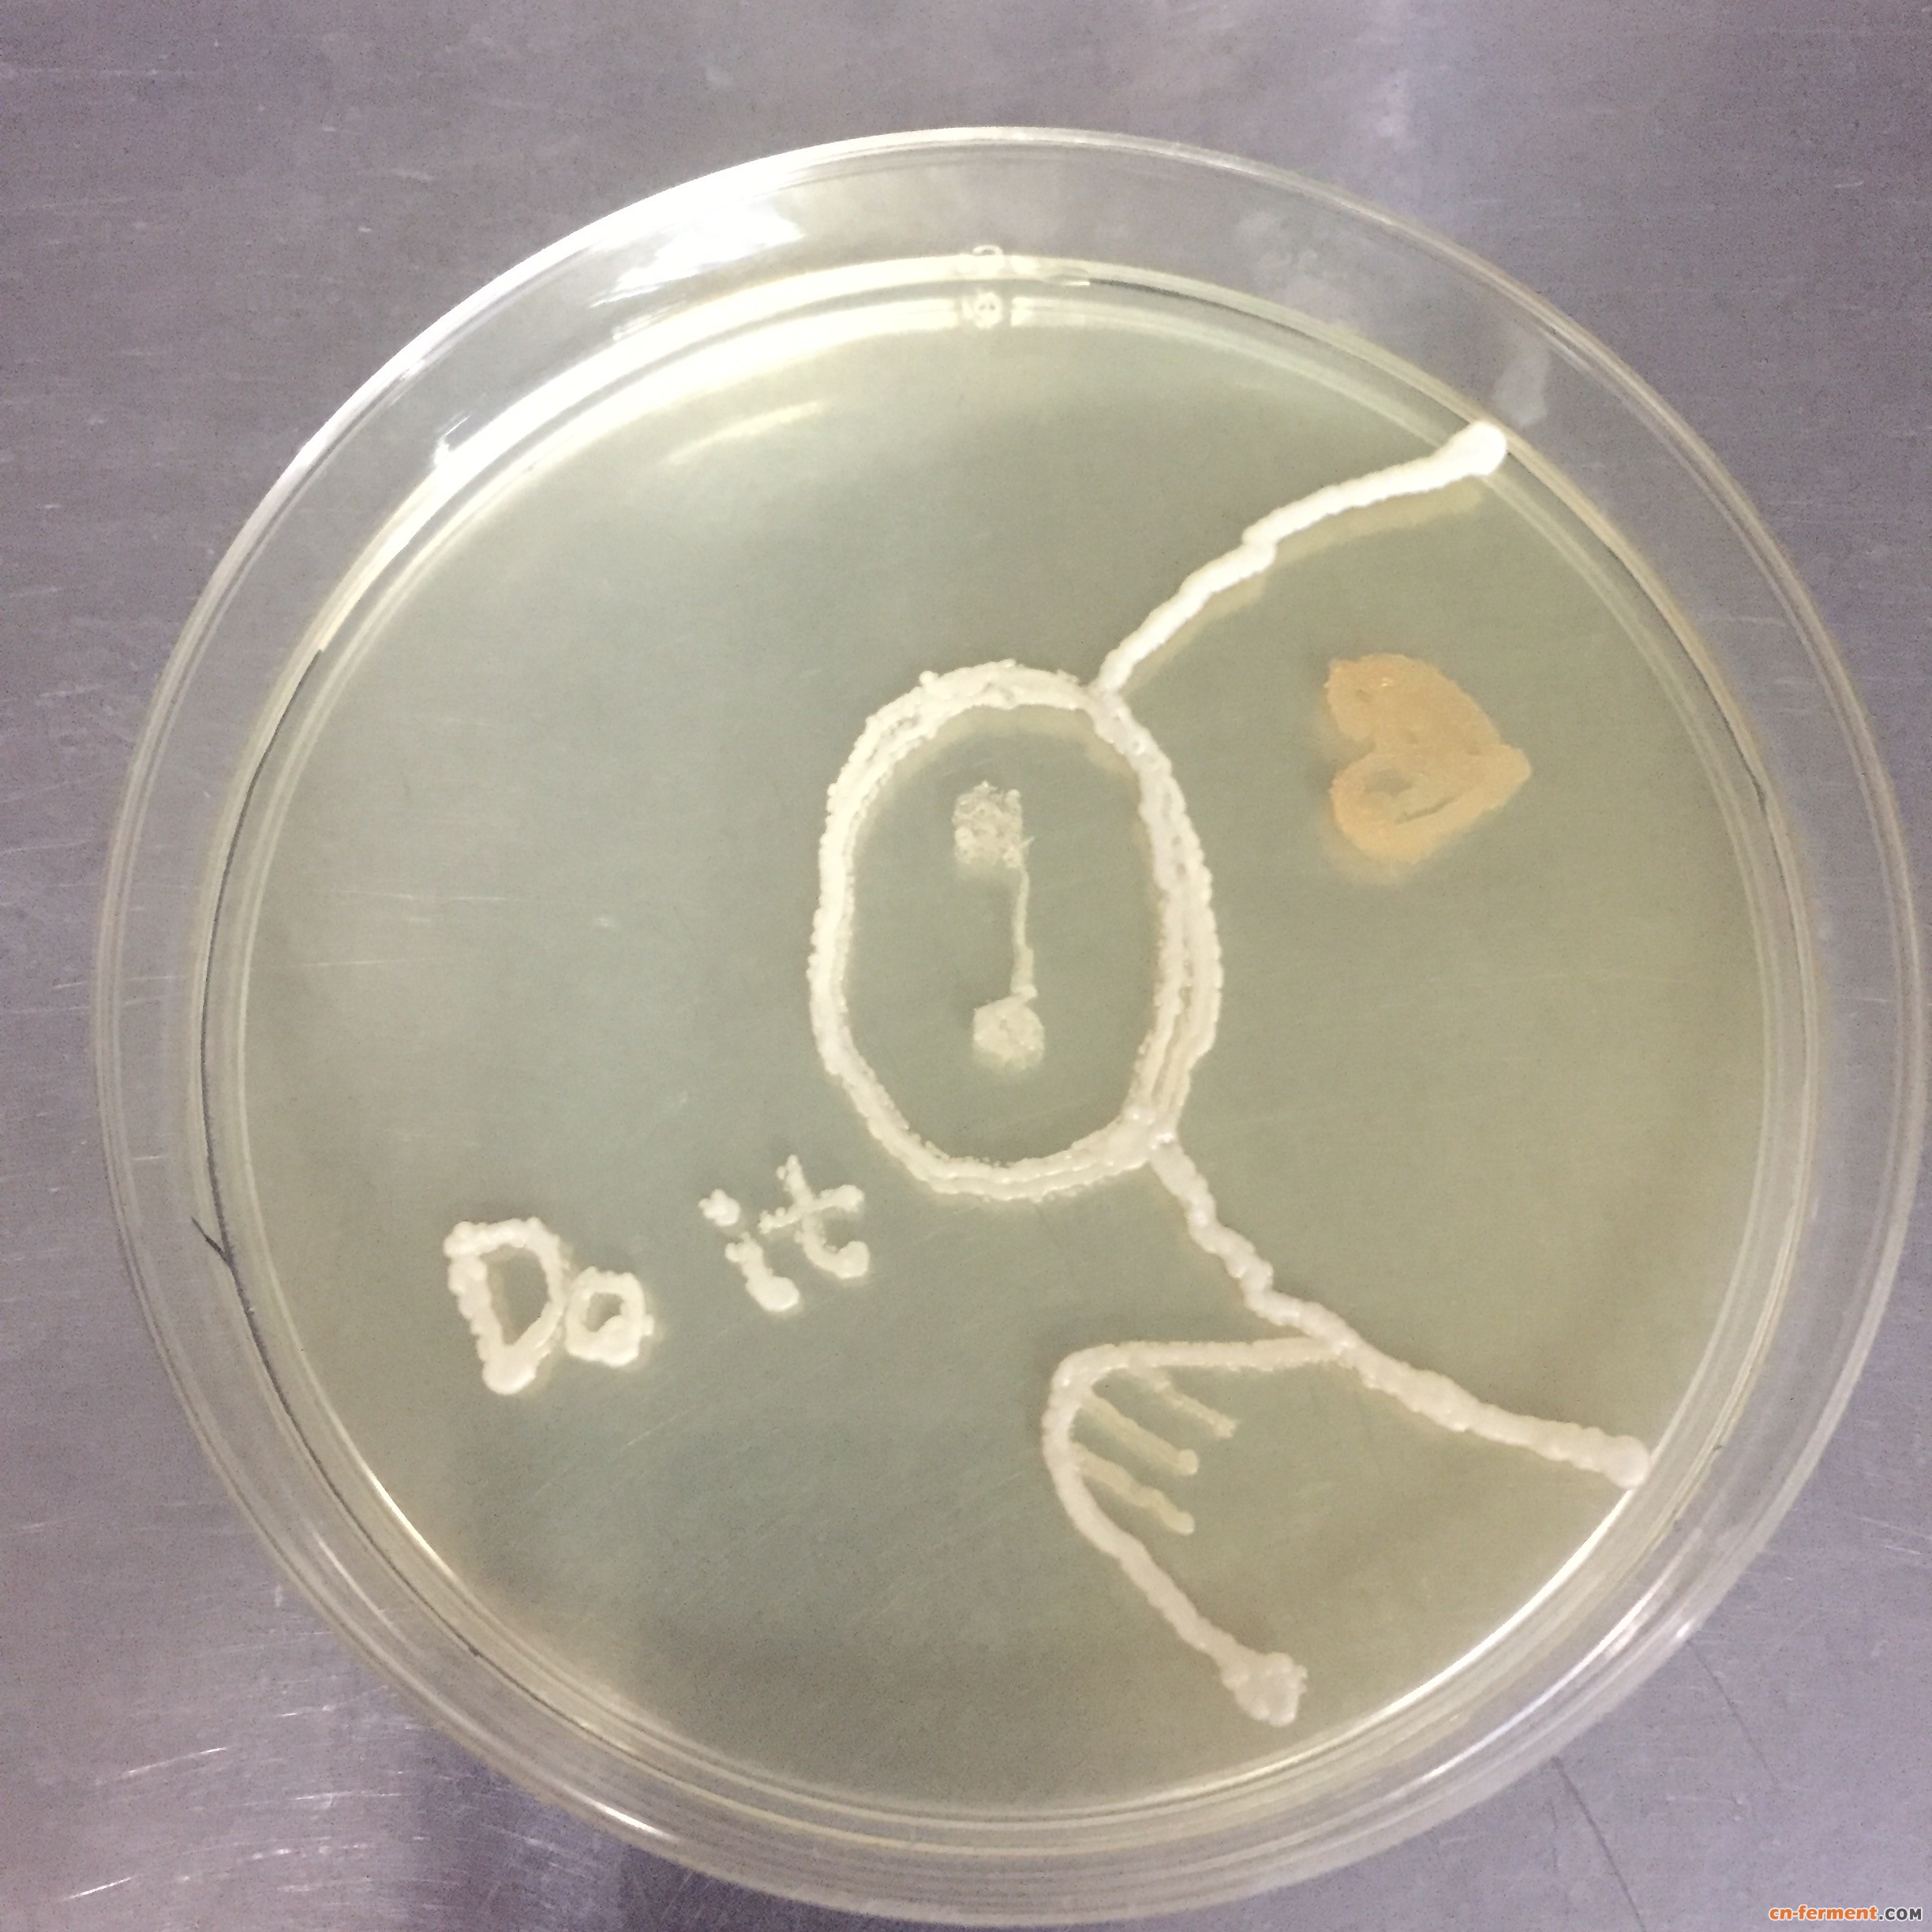
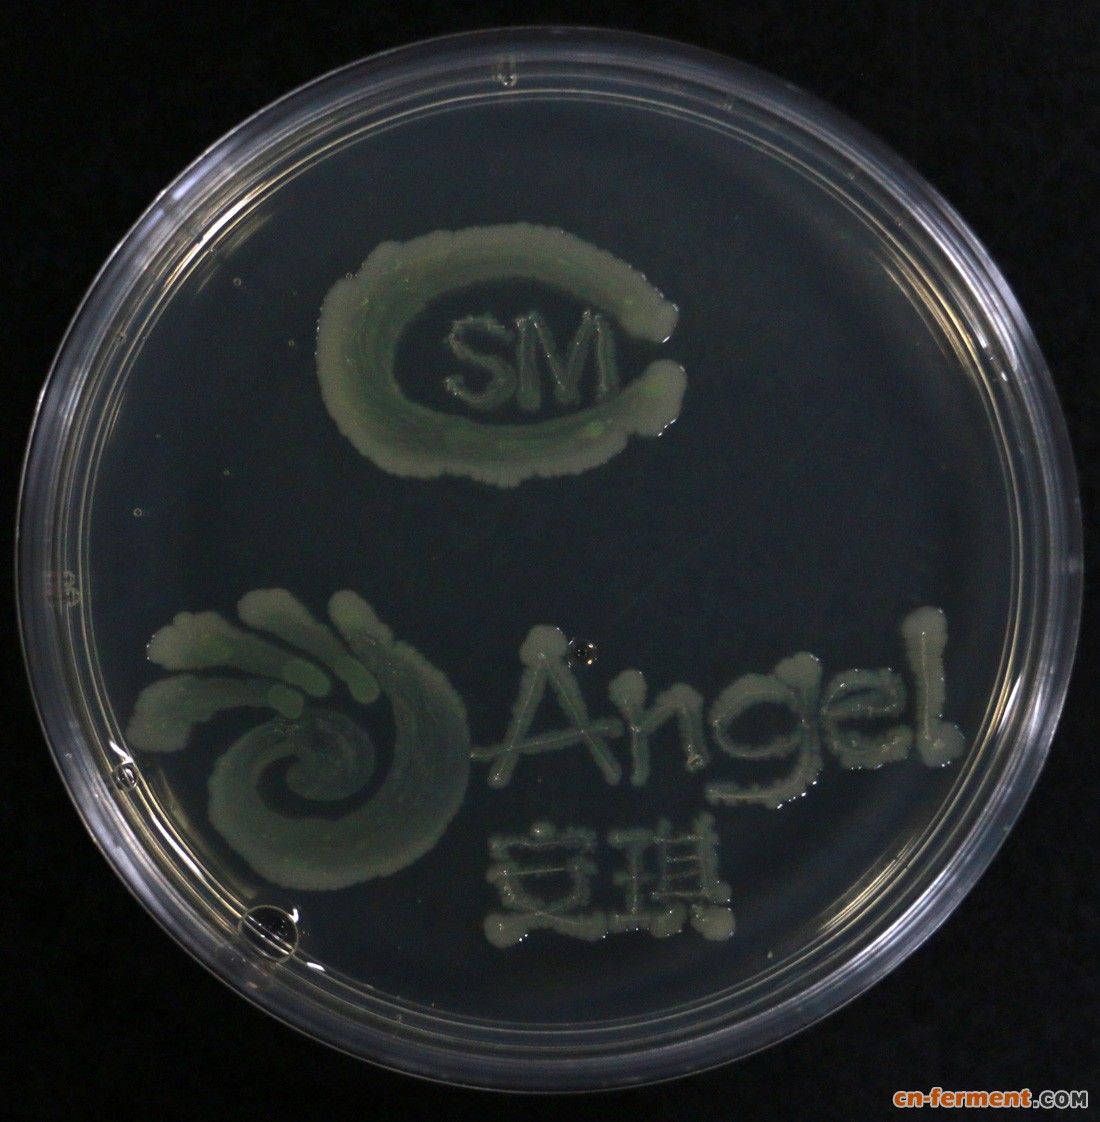

中国微生物学会“第一届中国微生物培养皿艺术大赛”8月1日一开启,就陆续收到了来自全国高校、科研院所和生物相关企业科研工作者的注册投稿,美轮美奂的培养皿艺术作品是目不暇接……
更为惊奇的是生物界还隐藏着不少“国画大师”。用培养皿当纸,以微生物做笔,书写古诗词,描绘梅兰竹菊,将经典国画呈现得淋漓尽致,令人叹为观止!

细菌诗画——作者:范世航

我爱中国——作者:李莹

显微镜—— 作者: 翟璐
风姿 菊——作者:张清
风姿 梅——作者:张清


满天星——作者:龚艳丽
大白——作者:向腊

赋予梦想的花——作者:骆明霞
主办方、承办方LOGO——作者:范世航
限于篇幅,在这就发这几幅!
想欣赏更多作品请登录到大赛官网吧



